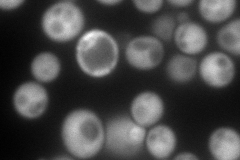
YLR109W
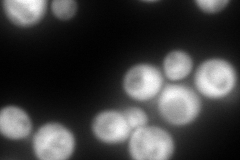
YLR109W
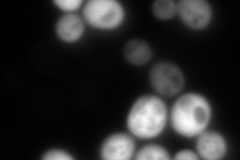
YLR109W
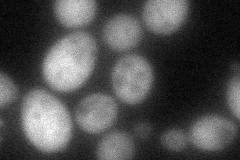
YLR109W

View description
Thiol-specific peroxiredoxin, reduces hydroperoxides to protect against oxidative damage; function in vivo requires covalent conjugation to Urm1p
Localization:
Intensity:
Fold change:
Significance:
-
C’ GFP library in SD

nucleus:cytosol2851.58 -
N' NOP1pr-GFP in SD
cytosol236.16 -
N' TEF2pr-mCherry in SD
cytosol340.777 -
N' NATIVEpr-GFP in SD
cytosol23.8997 -
N' TEF2pr-VC and Cyto-VN in SD
cytosol74.2408 -
C’ GFP library in SD+DTT

nucleus.cytosol2103.160.73Yes -
C’ GFP library in SD+H2O2

nucleus.cytosol2851.581No -
C’ GFP library in Starvation Media

nucleus,cytosol2851.581No -
C’ GFP library on the background of Pup2-DaMP

nucleus:cytosol -
C’ GFP library on the background of CCT mutant

nucleus:cytosol2103.170.737541Yes
